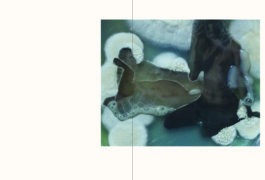
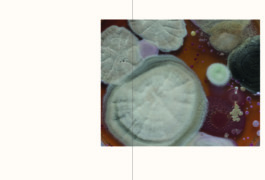

COLLINE
Fantaisie Erotique d’après Hans Emmenegger
2020-2021
Une montagne ? Un sein ?
Tes courbes. Ma muse.
À la vue des peintures de Hans Emmenegger, j’ai trouvé que le peintre traduisait une sensualité dans ses paysages. C’est de là qu’est partie mon envie de faire une forme de paysage corporel.
J’ai travaillé sur l’érotisation du paysage à travers la figure d’une muse qui compose elle-même le paysage. La muse naît dans des boîtes de Petri, si l’on veut la boîte de Petri est un incubateur à muse. La création de visuels par ces boîtes de Petri m’a permis de mettre en avant le geste répété de l’étude d’un paysage, le caractère de collectionneur, voir même obsessionnel, que possédait Hans Emmenegger, mais également son intérêt pour la science étant entre chimie et peinture. Ces boîtes sont également un clin d’oeil quant au rôle d’un musée dans son processus de conservation et de restauration ainsi que celui de collectionneur.
En outre je me suis intéressée à l’image érotique même, la façon dont on regarde. On commence par regarder l’évolution de la muse dans les boîtes de Petri, avec une certaine obsession à cause de la répétition du geste de création, il y a donc une forme de voyeurisme. Par la suite cette figure de muse sort de ces boîtes et de ces paysages fantasmés pour se retrouver dans le paysage réel, j’ai ici voulu copier le langage d’un voyeur observant cette muse à la longue vue.
Projet élaboré aux côtés de Philippe Jarrigeon
*Boite de Petri : « Une boîte de Petri est une boîte cylindrique transparente peu profonde, en verre ou en plastique, munie d'un couvercle. Facilement manipulable, empilable et peu coûteuse, elle est utilisée en microbiologie pour la mise en culture de micro-organismes, de bactéries ou de cellules d'organismes supérieurs (par exemple la culture d'hybridome). » (https://fr.wikipedia.org/wiki/Bo%C3%AEte_de_Petri, consulté le 3 février 2021)
COLLINE
Erotic Fantasy according to Hans Emmenegger
2020-2021
A mountain? A breast?
Your curves. My muse.
When I saw Hans Emmenegger's paintings, I found that the painter translated a sensuality in his landscapes. That's where my desire to make a kind of body landscape came from.
I worked on the eroticization of the landscape through the figure of a muse who composes the landscape herself. The muse is born in Petri dishes, basically the Petri dish is an incubator for the muse. The creation of visuals through these Petri dishes allowed me to highlight the repeated gesture of studying a landscape, but also the collector's character, even obsessive, that Hans Emmenegger possessed, as well as his interest in science always moving between chemistry and painting. These boxes are also a nod to the museum's role in the process of conservation and restoration as well as that of the collector.
In addition I was interested in the erotic image itself, the way we look. One begins by looking at the evolution of the muse in the Petri dishes, with a certain obsession because of the repetition of the gesture of creation, leading to a form of voyeurism. Then this muse's figure comes out of these boxes and fantasized landscapes to find itself in the real landscape. I wanted to copy the language of a voyeur observing this muse in the long run.
Project elaborated with Philippe Jarrigeon
*Petri dish: ‘’A Petri dish (alternatively known as a Petri plate or cell-culture dish) is a shallow transparent lidded dish that biologists use to hold growth medium in which cells can be cultured, originally, cells of bacteria, fungi and small mosses.'' (https://fr.wikipedia.org/wiki/Bo%C3%AEte_de_Petri, accessed February 3, 2021).

Une ré-adaptation du projet pour l'exposition au musée de l'Hermitage
A re-adaptation of the project for the exhibition at the Musée de l'Hermitage